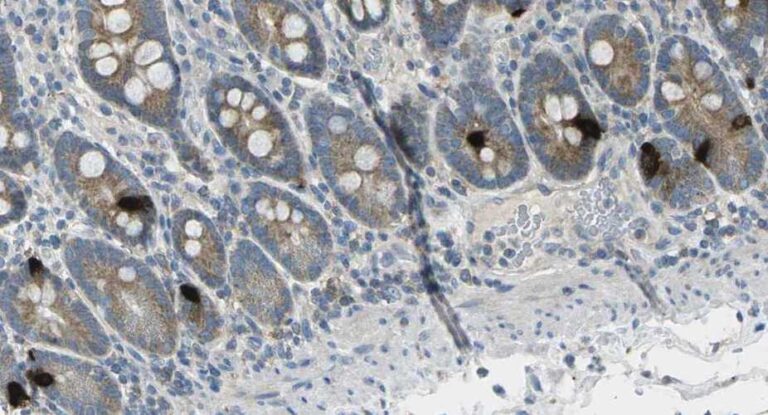

Anti-Gastric Inhibitory Polypeptide (GIP)
CAT NO: ABS 021-04
| Product Name | Anti-Gastric Inhibitory Polypeptide (GIP) |
| Description | Mouse monoclonal antibody |
| Isotype | IgG1/k |
| Host | Mouse |
| Clone | 4 |
| Conjugation | Unconjugated |
| Tested Applications | ELISA, IHC |


